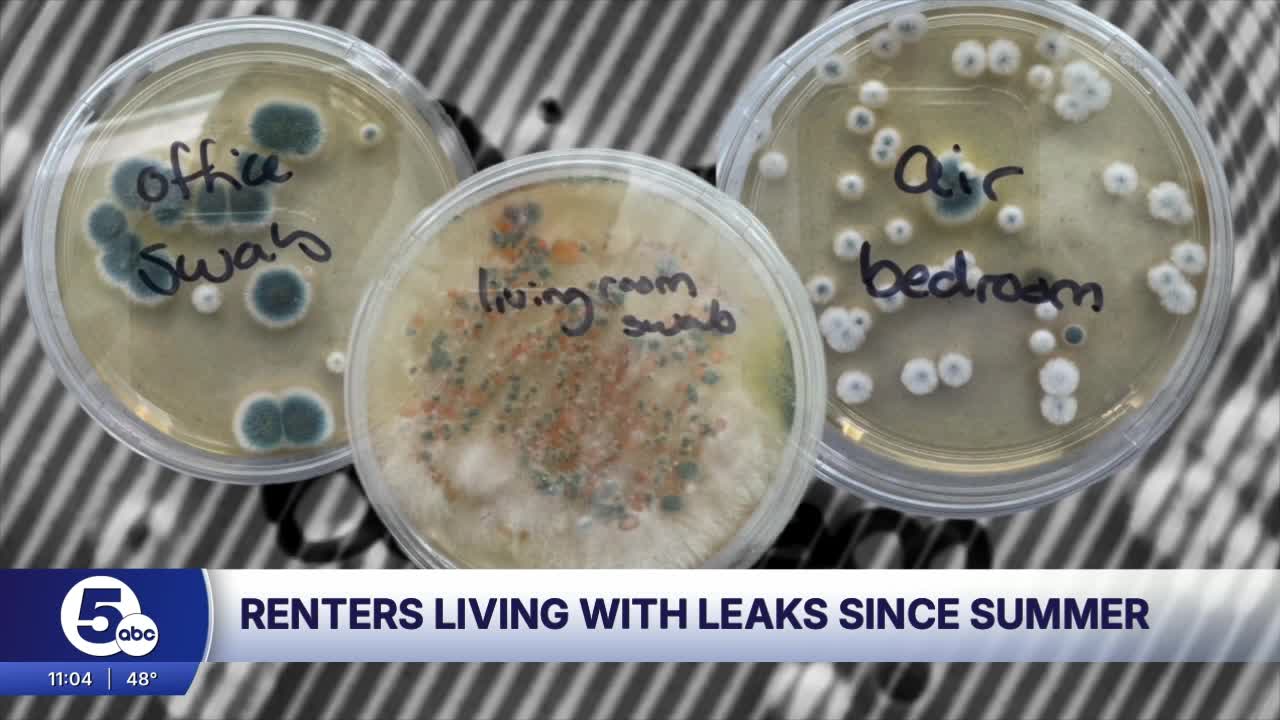

CLEVELAND, Ohio — A couple reached out to News 5 to list complaints about the lack of help they said they have received from Intro Cleveland due to numerous water leaks in their living room and two bedrooms.
“I lived in here for two weeks without a leak, and the rest of the time, 106 days, we’ve been dealing with a leak,” said Katarina Lechman.
From the moment the couple and their cat, Milo, moved into Intro Cleveland on July 12, Jack Johnson said they thought it was a dream come true.
“We just moved back from Charleston. We gotten engaged in April, and we were really looking to move in here,” said Johnson.
Then that excitement started to shift when Johnson said they saw water coming up through their apartment’s floorboards, so they reached out to their leasing office for help.
“They lifted up the floorboards and dried it up, and we came back and everything seemed fine at the time,” said Johnson.
But as weeks went by, Lechman said they realized the problem was far from over as they spotted more leaks in their living room and two bedrooms.
“It was active. There was water coming up constantly,” said Lechman.
After waiting and creating a 30-page document to record all the leaks, damages and interactions with management, the couple said they had to accept their property manager was not going to help them like they did the first time.
“They just haven’t really shown the same attentiveness or taken care of us,” said Johnson.
Now, after just a little over three months, the couple said they’re moving out because of mold concerns and the lack of help they said they received from their property manager to transfer them to a different unit for a cheaper cost.
“We’re just kind of sick and tired of dealing with this,” said Johnson.
Lechman said she reached out to Mayor Justin Bibb’s office on Instagram.
Within 20 minutes, she said someone from the Building and Housing Department called her and said they would come out sometime next week.
“I want to know that they’re never going to do this to anyone else. That they will fix the issues that are reported to them,” said Lechman about the apartment.
Intro Cleveland released a statement to News 5 Saturday afternoon regarding the ongoing issues:
We take all maintenance concerns seriously and seek to respond to all resident reports promptly and thoroughly.
We have hired independent contractors to investigate these issues.
Units with ongoing, unresolved issues are provided with options while we work toward solutions in the meantime.
Some residents have opted to stay in their current units and others have transferred within the building.
While water seepage has only impacted a minimal amount of units, INTRO Cleveland is committed to resolving these matters responsibly and transparently.